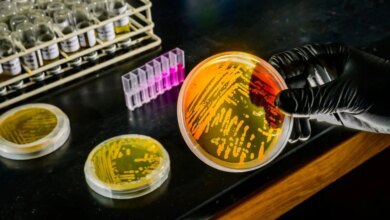

العلوم والتكنولوجيا
اكتشف الباحثون آلية مكافحة الشيخوخة السرية في الخلية


يساعد تنشيط التولد الحيوي للليزوسوم على تخفيف الشيخوخة الخلوية في مرض الشيخوخة المبكرة. متلازمة هاتشينسون-جيلفورد بروجيريا (HGPS) هي حالة وراثية نادرة تسبب الشيخوخة السريعة ومجموعة من الأعراض المرئية والداخلية. غالبًا ما يعاني الأفراد المصابون بـ HGPS من تجاعيد الجلد المبكرة، وانخفاض مرونة الجلد، وفقدان الدهون في الجسم تحت الجلد، وتساقط الشعر، وتصلب الشرايين (تصلب الشرايين)، (…)
نشر لأول مرة على: scitechdaily.com
تاريخ النشر: 2025-10-15 17:59:00
الكاتب: Science China Press
تنويه من موقع “بتوقيت بيروت”:
تم جلب هذا المحتوى بشكل آلي من المصدر:
scitechdaily.com
بتاريخ: 2025-10-15 17:59:00.
الآراء والمعلومات الواردة في هذا المقال لا تعبر بالضرورة عن رأي موقع “بتوقيت بيروت”، والمسؤولية الكاملة تقع على عاتق المصدر الأصلي.
ملاحظة: قد يتم استخدام الترجمة الآلية في بعض الأحيان لتوفير هذا المحتوى.
ظهرت المقالة اكتشف الباحثون آلية مكافحة الشيخوخة السرية في الخلية أولاً على بتوقيت بيروت | اخبار لبنان والعالم لحظة بلحظة.